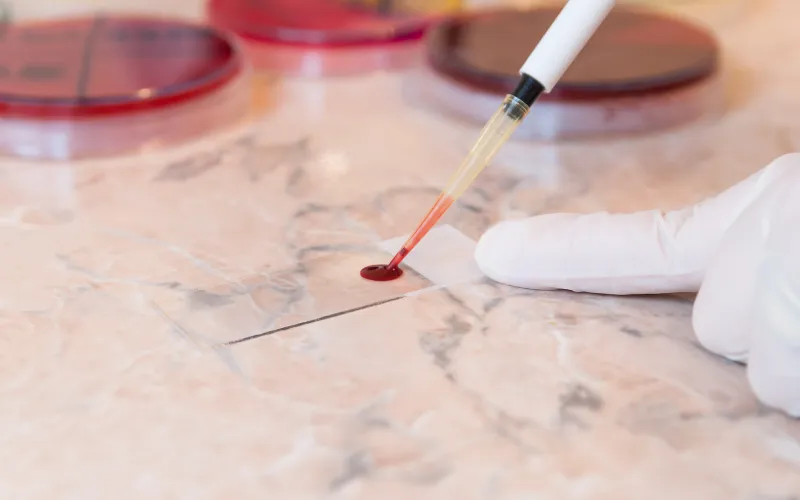
putting blood on blood slide

The Blood Disorders Center at Dana-Farber/Boston Children's provides comprehensive diagnostic, treatment, and preventive services for a wide range of non-malignant blood disorders.
Recall Alert
There are recalls of ibuprofen and eye drops. Learn more >>